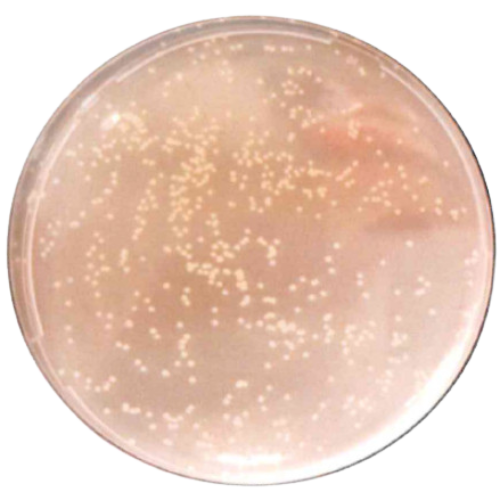
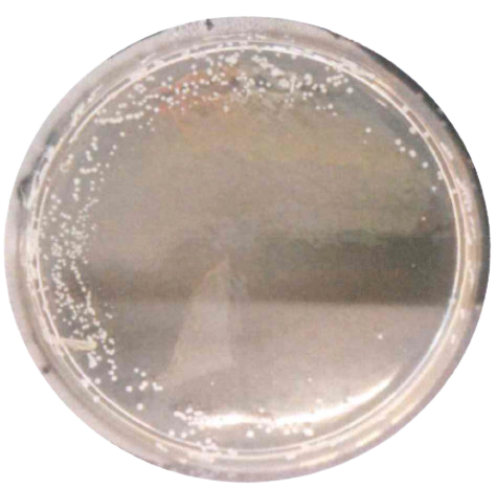

scopri TYFON
IL PRIMO SISTEMA D’IGIENE PER EROGATORI
D’ACQUA MEDICALMENTE CERTIFICATO CHE
TI ELIMINA PER SEMPRE L’ANSIA DELLA
RETRO-CONTAMINAZIONE BATTERICA
Protegge la Tua Reputazione sul Mercato
Senza Usare Lampade UV in Uscita. . .Senza Generatori di Ozono . . . 100% Automatico e Senza Manutenzioni da Gestire.
TYFON® Stermina al 99,999% i batteri pericolosi e disgustosi come Pseudomonas Aeruginosa, Staphylococcus Aureus e Saccharomyces Cerevisiae in Pochi Secondi.
Senza Fare Rumore, Senza Odore, E Senza Manutenzione Da Parte Tua.
Incredibili Foto Prima/Dopo Che Mostrano La Potenza Di Tyfon® Sui Batteri Più Pericolosi Per I Tuoi Clienti (E Per La Tua Reputazione Sul Mercato)
Acqua Prima dell'effetto di TYFON
“Ecco cosa stai bevendo davvero: Staphylococcus aereus
Quella che vedi non è acqua potabile. È un cocktail invisibile di germi vivi, pronti a invadere il tuo corpo.
Ogni puntino è una colonia attiva di Staphylococcus aureus: uno dei batteri più pericolosi, capace di causare infezioni cutanee, polmonari e perfino avvelenamenti del sangue.
Senza Tyfon®, questi batteri riescono a risalire dal beccuccio del tuo depuratore e contaminare l’acqua dopo la filtrazione.
Significa che li stai ingerendo vivi, ogni volta che bevi.
Li dai ai tuoi figli. Li usi per cucinare.
E loro? Si insediano nel tuo organismo… e iniziano il loro attacco.”

Acqua dopo l'effetto Tyfon
Questa è la prova che Tyfon® funziona.
Il trattamento automatico ha eliminato il 99.9999% dei batteri Staphylococcus aureus presenti all’uscita dell’erogatore.
Nessuna crescita. Nessun rischio. Nessuna preoccupazione.
Solo acqua pura, sterile, realmente sicura per te e per la tua famiglia.
E tutto questo… senza rumori, senza manutenzioni, senza sostanze tossiche.
Tyfon® protegge dove gli altri depuratori falliscono.

Acqua prima dell'effetto Tyfon
Ogni striatura è un segnale diproliferazionemicotica attiva!
Stai guardando il Staphylococcus aereus, unfungo invisibile aocchio nudo madevastante perla tua salute. Si annida neibeccucci deidepuratori, sinutredell’umidità erientranell’acqua dopola filtrazione,dove cresceindisturbato.Una voltaingerito, puòalterare la floraintestinale,scatenareallergie, gonfioreaddominale,infezioni urinariee disturbiimmunitari.E la partepeggiore? Nonha odore. Non hasapore. Ma èvivo. E ti entradentro.Se non lo fermi,ogni sorso è unaminaccia.
Acqua dopo l'effetto Tyfon
Dove prima c’era un’invasione fungina… ora c’è il nulla
Dopo l’intervento di Tyfon®, non resta più nulla: nessuna colonia, nessuna spora, nessuna minaccia.
Il sistema ha neutralizzato Saccharomyces cerevisiae alla radice, impedendo la formazione del biofilm e bloccando la retro-contaminazione.
Ciò che resta è solo acqua veramente pura, che puoi bere, usare e offrire con totale tranquillità.
Con Tyfon®, anche i microrganismi più resistenti vengono sradicati all’origine — senza ozono, senza UV, senza compromessi.

Acqua prima dell'effetto Tyfon
Sembra solo scuro. Ma è un terreno di morte.
Ciò che stai guardando è un’esplosione batterica invisibile, dominata dal Pseudomonas aeruginosa — un killer silenzioso che si annida nei beccucci, nelle vaschette, nelle micro-gocce d’acqua.
Un batterio in grado di resistere ai disinfettanti comuni, creare biofilm e invadere il tuo impianto dopo la filtrazione.
Una volta nel tuo bicchiere, può causare infezioni polmonari, irritazioni cutanee, otiti, problemi gastrointestinali.
E tu lo bevi. Senza saperlo

Acqua dopo dell'effetto Tyfon
Pseudomonas? Sradicato. Totalmente.
Tyfon® ha cancellato ogni traccia di contaminazione: nessuna colonia, nessun biofilm, nessuna zona grigia.
L’intero campo batterico è stato neutralizzato in automatico, grazie all’azione costante, silenziosa e clinicamente testata della tecnologia Tyfon®.
Nessun rischio. Nessuna incertezza. Nessuna risalita.
Con Tyfon®, anche i batteri più resistenti non hanno scampo.

Se vuoi semplificarti il lavoro, essere sempre un passo avanti per innovazione e tecnologia e avere una gamma di prodotti in costante espansione, puoi farlo grazie ai frigo gasatori OnnWater:
veloci da installare e made in Italy.


Gli unici con i brevetti:

COOL-HYBRID ©
Tanta acqua fredda in ogni condizione di temperatura, dell’acqua in ingresso e dell’ambiente

TYFON ©
Formazione di batteri nell’ugello di erogazione e nella vaschetta raccogli gocce eliminata al 99%

KARBONY ©
L'Unica acqua frizzante al mondo che NON provoca acidità di stomaco e che NON perde mai le bollicine
Stop agli interventi di manutenzione d’emergenza
Da oggi è possibile ridurre al minimo gli interventi d’emergenza o inaspettati e portare quelli ordinari al livello massimo di riuscita.
Tutto questo grazie al VISION SERVICE® di OnnWater, il sistema di telemetria che può essere collegato, tramite un’applicazione dedicata, ad ogni nostro frigo gasatore.
Uno dei problemi che fanno perdere più tempo per il rivenditore dal lato commerciale e dal lato tecnico, oltre a soldi e fiducia da parte dell’utente, che si ritrova con il frigo gasatore non funzionante, è dover intervenire in situazioni di emergenza.

LA NOSTRA SOLUZIONE:
IL SISTEMA DI MANUTENZIONE PREDITTIVA
Monitoraggio continuo online delle condizioni dei frigo gasatori installati, tramite un sistema di telemetria.
-
QUALI SONO I RISULTATI:
- Programmazione del momento ideale e più conveniente per la manutenzione, sia ordinaria che straordinaria
- Aumento del 25% della produttività degli installatori
- Riduzione del 70% dei guasti e cali di prestazione
- Riduzione del 25% dei costi di manutenzione
del nostro sistema di IoT innovativo:
-
Vantaggi TECNICI
- Prevedere con certezza quali strumenti e ricambi portare per l’intervento
- Conoscere a distanza, direttamente dalla tua azienda, lo stato di ogni frigo gasatore, gli eventuali problemi e il momento in cui i componenti consumabili (come filtro e bombola del co2) devono essere sostituiti
- Scegliere quali parametri, allarmi e comunicazioni rendere disponibili anche all’utente
-
Vantaggi COMMERCIALI
- Nuovo argomento commerciale da poter sfruttare nella tua comunicazione
- Frigo gasatori all’avanguardia anche dal lato 4.0 e che seguono il trend della digitalizzazione
- Miglior servizio clienti

COME FUNZIONA
In modo semplice ed efficace: VISION SERVICE® funziona tramite una app dedicata, disponibile sia per IOS che per ANDROID, che si collega al frigo gasatore tramite wi-fi.
PRENOTA UNA CHIAMATA
CON UN NOSTRO CONSULENTE


-
Per il rivenditore
- Tempi di ricezione merce da 15 a 20 giorni, perché siamo produttori diretti
- Nuovi argomenti commerciali da sfruttare
- Tempi di consegna al cliente finale ridotti, grazie al kit di trasformazione che adatta facilmente e in sicurezza il modello del refrigeratore in base alle richieste ricevute
- Sistema di collaudo Fixless, che garantisce l’affidabilità del prodotto senza margine di errore
- Prodotti di design e manifattura italiana: ogni componente è progettato, sviluppato e testato internamente da OnnWater
- Prodotti personalizzabili sia dal lato estetico che dal lato funzionale (inteso tipi di funzionalità)
- Tecnologie brevettate e innovazione costante

-
Per l'installatore
- Massima semplicità di montaggio, in massimo 20 minuti
- Nessun intervento invasivo o di muratura
- Manutenzione rapida: cambia bombola e filtro in 2 minuti
- Accesso ai componenti interni senza viti
- Stop agli interventi di emergenza

-
Per l'utente
- Grandi quantità di acqua fredda in ogni condizione d’uso e di temperatura, grazie al brevetto COOL-HYBRID©
- Tranquillità sulla sicurezza igienica e le perdite d’acqua (ogni dispositivo ha sensori di perdite piazzati in ogni punto critico, e questo abbassa drasticamente il rischio che il frigo gasatore abbia delle perdite e quindi causi danni all’ambiente circostante)
- Massima adattabilità in ogni ambiente e cucina
- Estetica di design salvaspazio
- Utilizzo intuitivo e connessione 4.0
PRENOTA LA CONSULENZA GRATUITA
COME REALIZZIAMO I NOSTRI REFRIGERATORI D’ACQUA
Progettiamo, sviluppiamo e testiamo internamente i refrigeratori OnnWater per garantire il massimo delle prestazioni.
I nostri componenti sono prodotti su misura e perciò hanno funzionalità flessibili e semplicità di gestione.
Supportiamo i nostri rivenditori con l’assistenza dedicata e la possibilità di collaborare e crescere insieme.


Facciamo tutto questo perché crediamo nella crescita del mercato italiano ed internazionale basata sull’eccellenza, l’innovazione costante e la risposta efficace alle necessità dei clienti.
Distinguiti sul mercato grazie alle performance della gamma di refrigeratori d’acqua OnnWater e alla garanzia dei nostri brevetti.
SISTEMA DI COLLAUDO FIXLESS
Garantiamo l'affidabilità dei nostri prodotti senza margine di errore.
Come Funziona:
I fornitori pre-testano i componenti grazie ai macchinari speciali di OnnWater
Controllo di qualità dei componenti nella nostra sede
Fase di montaggio e pre-collaudo del sistema frigorifero
60 minuti di collaudo del prodotto finito
Imballo speciale anti danneggiamento da trasporto
SISTEMA DI COLLAUDO FIXLESS
Garantiamo l'affidabilità dei nostri prodotti senza margine di errore.
Come Funziona:
I fornitori pre-testano i componenti grazie ai macchinari speciali di OnnWater
Controllo di qualità dei componenti nella nostra sede
Fase di montaggio e pre-collaudo del sistema frigorifero
60 minuti di collaudo del prodotto finito
Imballo speciale anti danneggiamento da trasporto
SCOPRI QUI I BENEFICI DI OFFRIRE UNA GAMMA DI PRODOTTI BREVETTATI E DISTINGUITI CON NUOVI ARGOMENTI COMMERCIALI.
I nostri Brevetti:

-
Cool–Hybrid
- + 30%capacità di raffreddamento superiore rispetto al banco di ghiaccio e al sistema a secco.
- Erogazione di grandi quantità d’acqua senza mai perderne la freschezza.
- Performance anche in piena estate o con l’erogatore posizionato in luoghi chiusi e poco ventilati.
- Nessuna manutenzione.
- Non usa refrigeranti.
- Sistema sigillato ermeticamente.

-
Tyfon
- Ugello di erogazione e vaschetta raccogli gocce sempre sterilizzati grazie al plasma freddo.
- Zero formazione di batteri sia nella vaschetta raccogli gocce che nell’ugello di erogazione.
- Nessuna possibile contaminazione da agenti esterni.
- Manutenzione una volta l’anno, in 3-5 minuti.
- Senza componenti chimici inodore.
- Sterilizza la vaschetta raccogli gocce.
- Non dannoso per la salute.

-
Karbony
- Effervescenza e conservazione della gasatura uniche nel settore.
- Preciso rapporto tra Co2, H2o e temperatura.
- Nessuna manutenzione.
- Livello di gasatura dell’acqua regolabile.
PRENOTA LA CONSULENZA GRATUITA
CAPACITA’ PRODUTTIVA ATTUALE DI ONNWATER,
AZIENDA ITALIANA ESPERTA DI FRIGO GASATORI
Entro i prossimi anni saremo in grado di duplicare tale capacità grazie a nuove linee produttive che sfrutteranno innovative pratiche di progettazione e gestione.


















